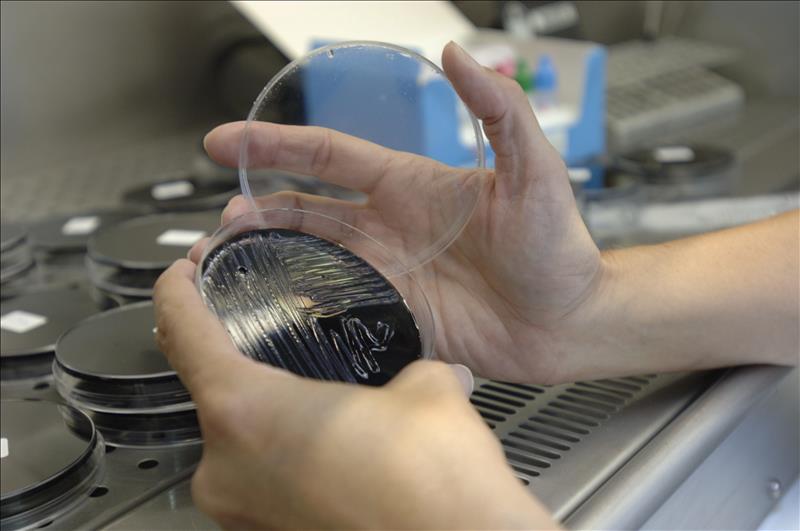
Seis afectados por un brote de legionela en una urbanización de Valencia Seis afectados por un brote de legionela en una urbanización de Valencia

Según la OMS
20/08/2018 11:46
Récord de casos de sarampión en Europa con 41.000 infectados en los primeros seis meses de 2018
Más de 41.000 niños y adultos en la Región Europea de la Organización Mundial de la Salud (OMS) han contraído sarampión en los primeros seis meses del año, un número que excede "por mucho" el total de afectados que se haya registrado en un periodo de un año durante la última década.